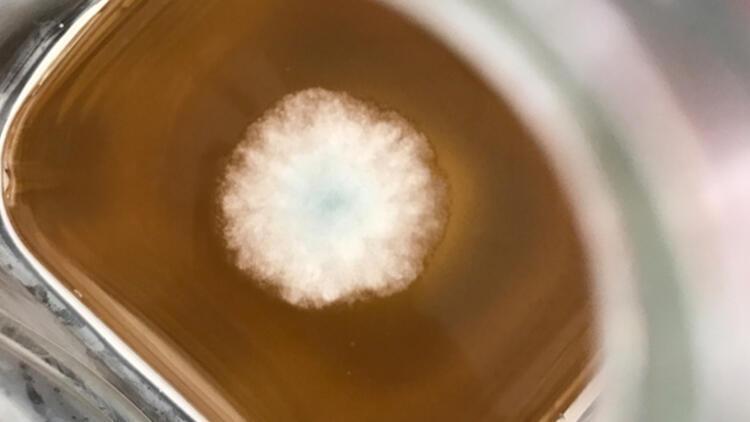
Meyve suyunun içinden küf çıkması tamamen üretimsel bir hata mı

Gıdada doğru bilinen yanlışlar: Yumurta, bal, tavuk bildiğimiz gibi değilmiş!
08.06.2022 - 15:50 | Son Güncellenme:
Hangi besinlerin daha sağlıklı ve organik olduğuna dair yüzlerce iddia var. En tehlikeli olanı da birçok kişinin gıda alanında uzman olmayan kişilerden, çevresinden duyduğu bu iddiaları doğru olarak kabul ederek uygulamaya çalışması. Hatta öyle ki bazen doğru bildiğimiz yanlışlar yüzünden vücudumuza gereksiz kısıtlamalar getirip dengeli beslenmeyi iyice zorlaştırıyoruz. Dondurulmuş gıdalar besin değerini kaybeder mi? Tavuklara antibiyotik veriliyor mu? Yumurta sarısı tazeliği hakkında bilgi verir mi? Meyve suları çürük meyvelerden mi üretilir? Gıda Mühendisi Ebru Akdağ, gıda alanında doğru bilinen yanlışların ardındaki gerçekleri milliyet.com.tr okurları için anlattı.

RÖPORTAJ: SENİM TANAY KARAKUŞ
senim.tanay@milliyet.com.tr
Her dönemin cevabı en merak edilen sorusuyla başlamak istiyorum: Ambalajlı sütler dediğimiz UHT yöntemiyle üretilen uzun ömürlü sütler sağlık için zararlı mı? “UHT edilmiş sütün hiçbir faydası yok”, “İçine ilaç katıyorlar”, “UHT süt bağımlılık yaratıyor” iddialarında bulunanlar var.
Bunların hepsi hurafe… UHT (Ultra High Temperature), 1961’den bu yana sıvı gıda işlemesinde tüm dünyada kullanılan yüksek teknolojidir. Süt, 135–150ºC’de 2 – 6 saniye gibi bir kısa sürede ısıtılıp soğutulduktan sonra aseptik (mikroplardan arındırılmış) koşulda, steril altı katmanlı ambalajlara doldurulur.

Ambalajı açılmazsa da oda sıcaklığında uzun süre besin değerini korur. Yani UHT süt hem ısıl işlem hem de ambalajlama teknolojisi sayesinde hiçbir koruyucu katkı maddesine gerek olmadan besin değerinin korunduğu bir üründür.

Pastörize günlük süt, UHT sütten daha fazla vitamin ve mineral mi içeriyor? Yani daha mı faydalı?
Pastörizasyon 72 derecede 15 saniye civarında yapılır. İlk kez 1860'larda Fransız bilim insanı Louis Pasteur tarafından geliştirilen bu yöntem, mikroorganizmaların ısı yardımıyla tahrip edilmesi esasına dayanır.
UHT ve pastörize süt ile çiğ süt arasında besin değeri açısından önemli bir fark olmadığı bilimsel araştırmalarla ortaya konmuştur. Ancak pastörize sütün besin değeri az da olsa UHT’den daha yüksektir. Hastalık yapma riski açısından ise UHT ve pastörize sütte sorun yokken sokak sütü endişelerin ana kaynağıdır.

Kimimiz evde dondurma yöntemi uygulayarak bazı gıdaları depoluyoruz kimimiz de paketli dondurulmuş gıdalara yöneliyoruz. Dondurulmuş gıdanın besin değer değişir mi? İçine koruyucu konuluyor mu?
Dondurulmuş gıdalar, mevsiminde toplanmış meyve sebzelerin, yıkanıp temizlendikten sonra “tek tek dondurma” sistemi ile birkaç dakika içerisinde şoklanmasıyla üretilir. Bu şekilde, hiçbir koruyucu katkı maddesi eklenmeden besin değerini raf ömrü boyunca korur. Hatta yapılan araştırmalar dondurulmuş meyve sebzenin besin değerinin pazardan, marketten alınanlardan genellikle daha yüksek olduğunu ortaya koyar.

Çünkü dalından kopartılan, kökünden ayrılan meyve ve sebzeler, ilk andan itibaren besin değerini kaybetmeye başlar ve markete gelene kadar genelde yaklaşık 1 haftalık yolculuğu vardır. Bu esnada da besin değerini kaybeder. Dondurulmuş ürünler ise hasattan saatler sonra şoklandığı ve kullanılan teknoloji sayesinde, besin değerini muhafaza eder.

Yıllardır pek çok kişinin mutfağından uzak tutmaya çalıştığı margarin, trans yağ ve kolesterol içeriyor mu?
Margarin trans yağların riskleri bilinmediği zamanlarda trans yağ içeriyordu. Çünkü trans yağ ürüne eklenen bir şey değil, üretim esnasında istenmeden oluşuyordu. Riskleri ortaya çıkınca üretim teknolojisi değişti. Türkiye bu konuda dünyada trans yağsız üretime geçen ilk ülkelerden biridir.

15 yıldır ülkemizdeki margarinlerde trans yağ yok kabul edilen seviyenin altındadır. Kolesterol ise margarinle hiç bağdaştırılamaz çünkü kolesterol hayvansal gıdalarda olur. Halbuki margarin bitkisel yağların karışımından oluşur, dolayısıyla her bitkisel gıda gibi margarinler de kolesterol içermez.

Yumurtanın taze, doğal olduğunu belirlemek için ilk baktığımız şey sarısının rengi oluyor. Sadece gezen tavuk yumurtasının sarısı mı koyu olur?
Yumurtanın sarısının rengi, tavuğun cinsine ve beslenme şekline göre değişir. Kalite standardı olarak kullanmak doğru değil. Gezen tavuk yumurtasının besin değerinin diğerlerine kıyasla daha yüksek olduğunu gösteren kanıt da yoktur. Yumurtanızın tazeliğini anlamak istiyorsanız size test etmek için ipuçları verebilirim.

El feneriyle test:
Yumurtanın tazeliği, içeriğine bağlıdır. El fenerini yakıp yumurtanın sivri ucu ışığa bakacak şekilde tutun. Yumurta tazeliğini kaybettikçe içindeki hava boşluğunu büyüyecektir. Ayrıca döllenmiş bir yumurta altı gün kuluçkaya bırakılırsa cenin siyah iplikçik şeklinde görülebilir; şaşırmayın.

Dinleme testi:
Taze yumurtayı kulağınızın yakınında hafifçe sallarsanız hiçbir ses duymazsınız. Fakat aynı işlemi bayat yumurta ile gerçekleştirirseniz yumurtanın içerisindekilerin hareket ettiğini duyarsınız. Çünkü içerisindeki boşluk artmıştır.

Tutma testi:
Yumurtayı kırıp sarısını avucunuza alın. Nazikçe iki parmağınızla yumurta sarısını tuttuğunuzda, zarı patlamıyorsa yumurta taze demektir.
Elbette her gıdada olduğu gibi yumurta alırken de ambalajının üzerindeki son kullanma tarihine bakmalıyız.

Kahverengi kabuk rengine sahip yumurta beyaz kabuklu yumurtadan daha mı iyi?
Yumurtanın renginin kalitesiyle hiçbir bağlantısı yoktur. Aslına bakarsanız yumurtanın üstünlüğünü rengine bağlamak, tüy rengine bağlamaktan farklı değil. Tavuğun cinsi yumurtasının renginde belirleyici olan etkendir.

Tüyleri de kulak lopları da beyaz olan İtalyan Leghorn tavuklarının yumurtaları beyaz olur. Tüyleri kırmızı, sarı veya kahverengi olup kulak lopları kırmızı olan Avusturalyalı Orpington tavukları ise kahverengi yumurtalara sahiptir.

Başlangıçta her yumurta beyazdır. Renklenmesi yumurtanın tavuğun yumurtlama kanalındaki 26 saatlik yolculuğunun sonlarına doğru olur. Yumurtaya kahverengi rengini veren pigmentler yumurtanın oluşumundan sonra eklendiği için kabuğun sadece dış yüzü renkli olur.

Geç pişen tavuk doğal olan tavuk mudur?
Tavuğun geç pişmesi ırkıyla ve yaşlılığıyla ilişkilidir. Köyde yetiştirilen tavuklar genellikle kesme dönemine kadar yaşlandırılmış olduğu için etleri daha geç pişer. Endüstride en hızlı yetişen, kolay pişebilen körpe tavuk ırkları üretildiği için, markette aldığınız tavuk çok daha kolay pişecektir.

‘Hormonlu gıda’ denildiğinde akıllara gelen besinlerden biri de tavuk. Öyle ki “Artık eve tavuk almıyorum” diyen hatırı sayılır derecede fazla kişi var. Tavuklara antibiyotik veriliyor mu?
Türkiye’de dünyada olduğu gibi kümes hayvanlarında büyüme amaçlı hormon kullanımı yasaktır. Öte yandan bu hem teknik hem de maliyet açısından rasyonel değildir. Çünkü tavuk yemlerine büyüme hormonu katılması bir işe yaramaz, bunlar hayvanın midesine ulaştıklarında parçalanıp etkisiz hale gelirler.

Hormonun etkili olması için tavuklara enjekte edilmesi gerekir; hem de her gün ve günde bir defadan fazla. Bunun için yetiştiricinin bütün gününü tavuk kovalayarak geçirmesi gerekecektir. Sizce de binlerce tavuğun olduğu üretim hanelerinde her gün, her bir tavuğu birkaç kez yakalayıp enjeksiyon yapmak teknik açıdan anlamsız, maliyet açısından da saçmadır.

Sağlıklı hayvanları koruma amaçları dışında antibiyotiklerin büyütme amaçlı yem katkı maddesi olarak yemlere katılması yasaktır.

Antibiyotikle tedavi edilen bir hayvanın eti, sütü, yumurtası da antibiyotik içerir mi?
Ülkemizde antibiyotik kullanımına ilişkin yasal düzenlemeler AB mevzuatı ile uyumludur. Antibiyotik uygulaması sadece tedavi için hastalık durumunda veteriner hekimin yazdığı reçete doğrultusunda ilgili mevzuata uygun şekilde kullanılabilir.

Çünkü hasta hayvanların da tedavi edilmesi gerekir. Bunun insanlara bir etkisi olmaması için antibiyotik kullanılması durumunda her türlü riski ortadan kaldırmak adına kesimden önce ilaç arınma süresinin (bekleme süresi) dikkate alınması yasal zorunluluktur.

Bütün gıda katkı maddeleri kansere yol açar mı?
Hiçbiri kansere yol açmaz. Bir gıda katkı maddesinin kansere yol açabileceğiyle ilgili en ufak bir şüphe olsa o gıda katkı maddesinin kullanımına izin verilmez. Gıda katkı maddelerinin kullanılmasına izin verilmesi sürecinin arkasında uluslararası bir bilim ordusunun 10 – 15 yıllık çalışması yer alır.

Gıda katkı maddelerinin yönetiminden Birleşmiş Milletler Gıda ve Tarım Örgütü (FAO) ve Dünya Sağlık Örgütünün (WHO), Ortak Birleşik Gıda Katkıları Uzmanlar Komitesi (JECFA) sorumludur. Ayrıca Avrupa Gıda Güvenliği Otoritesi (EFSA) ve ABD Gıda ve İlaç Dairesi (FDA) gibi uluslararası gıda ve sağlık otoritelerinin de görüş birliği olması durumunda ilgili gıda katkısının kullanımına izin verilir.

Bırakın kanseri, katkı maddelerinin kullanımı öyle bir ayarlanır ki, bir insan 70 – 80 yıl yaşam ömrü boyunca, her gün o katkıyı tüketse dahi, hiçbir etkinin gözlemlenmeyeceği seviyeye izin verilir. Gıda katkılarına bırakın izin verilmesini, değerlendirme aşamasına geçebilmesi için bile insanlara fayda sağlayacak bir işlevinin olması gerekir. Avantajları arasında ise aşağıdakiler yer alır:

-Gıdada hastalık yapıcı mikroorganizmaların gelişmelerini önlemek,
-Gıdanın besleyici değerini korumak,
-Özgün diyet ihtiyaçları olan insanlara özel üretim,
-Lif, vitamin, mineraller gibi sağlığa olumlu etkisi olacak maddelerle güçlendirilerek besin değerinin artırılması,
-Daha uzun bir raf ömrü,
-Gıda israfının önlenmesi,
-Gıdanın dokusal özelliklerini, lezzetini, rengini geliştirmek,
-Gıda çeşitliliği sağlamak,
-Sağlık riski yaratan oksidasyon gibi istenmeyen reaksiyonları engellemek.

Tereyağın sarı ya da beyaz olması kalitesini mi ortaya koyar?
Tereyağının rengi hayvanın beslenme şekline ve besinlerinde belirleyici rol oynadığı için mevsimlere bağlıdır. Rengi tereyağı kalitesinin bir göstergesi değildir. Eğer sütü kullanılan inek, koyun ya da keçi çimen ve ot gibi yeşillik ağırlıklı beslenme şekline sahipse, bu yeşillikler içerisindeki karotenoid maddesi nedeniyle tereyağı daha sarımsı renge sahip olmaktadır.

Hayvanın besiniyle sütüne geçen karotenoidler, yağda çözünerek aynı zamanda tereyağına rengini verirler. Fakat tereyağı yapımında sütü kullanılan hayvan saman, arpa ve buğday gibi yemlerle besleniyorsa bu gıdalarda renk verici maddeler bulunmadığı için tereyağının daha açık renkte olması beklenir.

Ancak tüketiciler aynı renkte tereyağı beklentisinde olduğu için tereyağı üretiminde Kodeks’te izin verilen bitkisel ve mineral kaynaklı renklendirici maddelerin kullanılabilmektedir.

Balın kristalleşmesi o balın doğal, hakiki, halis bal olduğunu gösterir mi?
Balın kristalleşmesi normaldir. Ancak bu doğal, hakiki, halis veya başka bir çıkarım yapmak için geçerli bir gösterge değildir. Bal, türüne, saklama koşullarına, saklama uzunluğuna vb. gibi etkilere göre kristalleşebilir de kristalleşmeyebilir de.

Bal en kolay taklit edilebilen, öte yandan gerçekliği en zor anlaşılabilen gıdalardandır. Tüketici olarak bizim balın doğallığını, gerçekliğini anlamamız kesinlikle mümkün değildir. Bunun için çok sayıda özelliğine bakılan laboratuvar amaliz sonuçları yorumlanmalıdır.

Konserve ürün tüketmek sağlık için zararlı mı? Metal ambalaj içinde satılan konservelerde metalin gıdaya geçmesi söz konusu mu?
Konserveleme yöntemi Napolyon zamanında, ordunun hem yanında bozulmadan hem de besin değerini koruyarak saklayabileceği gıdalara ihtiyaç duymasıyla keşfedilmiştir. Konserve ürün tüketmenin sağlık açısından bir sakıncası olmadığı gibi sebze meyve tüketimini artırmak ve gıda israfını önlemek açısından da olumlu etkisi olabilir.

Taze veya dondurulmuş muadillerine kıyasla konserve gıdalardaki besin değeri biraz daha düşüktür. Ancak bu onları diğerlerine ulaşamadığımız zamanlarda veya yemek pişirmeye vakit olmadığında iyi bir gıda alternatifi olmaktan uzaklaştırmaz. Konservelerde kullanılan ambalajlar gıdaya herhangi bir geçiş olmaması için gerekli testlerden geçmişlerdir.

Bitki ve meyve çaylarının poşetinde plastik var mı?
Poşet çay sanıyorum biraz da ismi dolayısıyla yanlış anlaşılıyor çünkü poşet denildiğinde insanların aklına ilk gelen naylon oluyor. Halbuki poşet çayların poşetinin bununla hiç ilgisi yok. Türkiye’deki başlıca çay üreticilerinin kullandığı poşetler, muz ağacının kuzeni diyebileceğimiz muzgillerden Abaka ağacının liflerinden üretiliyor.

Nasıl ketenden üretilen gömlekler yağmurda erimiyorsa Abaka ağacından üretilen çay poşetleri de sıcak suda erimiyor ama çayın içeriğinin suya geçmesine olanak sağlıyor. Dolayısıyla bunlar bitkisel ürünlerdir.
Ambalajlı gıdalar paketlenirken içine karışan plastik vücutta birikip hasta eder mi?
Gıdaya uygun ambalaj kullanılmıyor veya gıda uygun koşullarda saklanıp kullanılmıyorsa ambalajdan gıdaya istenmeyen bileşiklerin geçişi olabilir. Bu da insan sağlığı açısından risk yaratır. Bunun için kayıt dışı ve açıkta satılan ürünlerin ambalaj gıda ilişkisine güvenemeyiz. Sadece yönetmeliklere uygun üretilmiş ve ambalajlanmış gıdalarda bir sorun olmamasını bekleriz.

Kontrolsüz satılan gıdalarda uygun ambalaj mı kullanılmış yoksa daha önce kullanılmış bir ambalajı tekrar mı kullanmış bilemeyiz. Gıdanın muhafazasında uygun olmayan kimyasallar içeren ambalajlar kullanılması, gıdaya geçen tüketime uygun olmayan kimyasalların vücutta birikmesine neden olabilir, bu da sağlık riski yaratabilir.

Ambalajlı gıdalar paketlenirken içine karışan plastik vücutta birikip hasta eder mi?
Gıdaya uygun ambalaj kullanılmıyor veya gıda uygun koşullarda saklanıp kullanılmıyorsa ambalajdan gıdaya istenmeyen bileşiklerin geçişi olabilir. Bu da insan sağlığı açısından risk yaratır. Bunun için kayıt dışı ve açıkta satılan ürünlerin ambalaj gıda ilişkisine güvenemeyiz. Sadece yönetmeliklere uygun üretilmiş ve ambalajlanmış gıdalarda bir sorun olmamasını bekleriz.

Kontrolsüz satılan gıdalarda uygun ambalaj mı kullanılmış yoksa daha önce kullanılmış bir ambalajı tekrar mı kullanmış bilemeyiz. Gıdanın muhafazasında uygun olmayan kimyasallar içeren ambalajlar kullanılması, gıdaya geçen tüketime uygun olmayan kimyasalların vücutta birikmesine neden olabilir, bu da sağlık riski yaratabilir.
Meyve suyunun içinden küf çıkması tamamen üretimsel bir hata mı?
%100 meyve suyu koruyucu katkı maddesi konulması yasak olan ve dolayısıyla yüksek besin değeriyle kolay bozulmaya yatkın bir üründür. Meyve suyunda küf oluşumu üretim hatasından kaynaklanabilir. Ancak böyle bir durum üretim hattında yapılan rutin kontrollerde tespit edilir ve ilgili parti ürün imha edilir.

Küflü meyve suyunun tadı kötü olabileceği gibi ambalajı da şişme yapar. Yani satılabilecek bir ürün olmaktan çıkar. Üreticiler üretimin kritik her aşamasında örnek alarak laboratuvarda ürünü analiz eder.

Meyve suyundan çıkan küfün temel nedeni aslında üretimden çok daha büyük ihtimalle nakliye, satış kanallarında ambalaj zedelenmesi dolayısıyla olur. Ambalaj delinir, yırtılır ve meyve suyu havayla dolayısıyla mikroorganizmalarla buluşursa bozulma başlar. Bir diğer sık rastlanan tüketici kullanımı hatasıdır.

Meyve suyu kapağı açıldıktan sonra buzdolabında saklanmalı ve en fazla 3-4 içinde tüketilmelidir. Doğru saklama koşulları ve saklama ömrüne uyulmaması durumunda meyve suyunda küf oluşur. Zaten bu da meyve suyunda koruyucu olmadığının bir göstergesidir.

%100 meyve suları gerçekten katkısız mı?
%100 meyve sularına şeker, tatlandırıcı, aroma verici, renklendirici koruyucu vb. katkı maddelerinin eklenmesi yasaktır. Yani bunlar evinizde sıktığınız meyve suyuna çok benzerdir. En büyük fark, raf ömrü boyunca bozulmadan besin değerinin korunabilmesi için ısıl işlemden geçmesidir.

Meyve suları çürük meyvelerden mi üretilir?
Meyve suyunun yasal düzenlemedeki tanımında “sağlam, olgun, taze veya soğukta ya da dondurularak muhafaza edilmiş” meyvelerden üretilmesi gerektiği ifade edilir. Çürük meyveden meyve suyu elde etmek mümkün değildir. Ancak nasıl kilolarca meyve alırsak aralarında çürüğe rastlamak mümkünse fabrikaya gelen tonlarca meyve arasında da çürükler olması doğaldır.

Bu nedenle meyve suyu üretimine geçişte ilk basamak “ayırma”dır. Hareketli bantta ilerleyen meyvelerin başındaki çalışanlara verilen talimat “Yiyemeyeceğin meyveyi ayır” şeklindedir. Bu sadece çürük olanlar için değil, ham olanlar için de geçerlidir. Eğer fabrikaya gelen kamyondaki meyvelerde çürük oranı yüksekse meyveler kabul edilmez.

Gıdaların mikrodalgada ısıtılması herhangi bir sağlık riski yaratır mı?
Mikrodalgalar bir "elektromanyetik" radyasyon biçimidir. Bunlar hücrelere zarar verebilen iyonlaştırıcı radyasyondan farklıdır. Mikrodalgalar, radarlarda, telefon, televizyon, saç kurutma makinesi gibi ev aletlerinde kullanılır.

Sonuçta mikrodalga fırında pişirilen gıdaların "radyoaktif" hale geldiği büyük bir hurafedir. Bilimsel araştırmalar, bakımlı ve kullanım kılavuzuna uygun şekilde kullanılan mikrodalga fırınların güvenli olduğunu ortaya koyar. Eğer saç kurutma makinenizden korkmuyorsanız mikrodalga fırınınızdan korkmanıza da gerek yoktur.

Diyet ürünlere şeker yerine glikoz şurubu, elma suyu konsantresi, yüksek fruktozlu mısır şurubu mu ekleniyor?
Glikoz şurubu, elma suyu konsantresi ve yüksek fruktozlu mısır şurubu birbirinden çok farklı değildir. Bunların hepsi formülleri birbirine çok yakın şeker gruplarıdır. Dolayısıyla bir ürüne bunlardan biri yerine diğerinin eklenmesi onu diyet ürün haline getirmez.

Kaya tuzu birçok hastalığın önlemesinde etkili mi?
Tuz tuzdur. Kaya tuzunun herhangi bir üstünlüğü yoktur. Kaya tuzu, bildiğimiz sofra tuzunun çok az miktarda başka elementlerle karışmış halinden başka bir şey değil.
Bilimsel çalışmalar aşırı tuz tüketimi ile kalp, damar hastalıkları ve özellikle hipertansiyon ilişkisini ortaya koymuştur. Bu etkilerin sorumlusu, tuzun ana maddesi sodyumun aşırı alımıdır. Kaya tuzunun da yüzde 97’si, asıl bileşeni “sodyum” olduğuna göre, onun da aşırı tüketimi sağlık açısından sakıncalı olacaktır.

Kaya tuzlarının, çok sayıda mineral içerdiği için birçok hastalığın önlenmesinde etkili olduğu söylentisi hurafedir. Evet, kaya tuzunun yapısında başka bazı elementler de bulunur ancak bunlar eser miktarlarda yani sağlık üzerine etki edemeyecek kadar az düzeydedir.

Öte yandan kaya tuzlarının bileşiminde, insan sağlığı açısında “çok riskli” olduğu bilinen plütonyum, talyum ve radyum gibi maddeler ve “kurşun” gibi ağır metallerin de bulunduğundan ise pek bahsedilmez nedense. Ancak korkmayın, bunlar da yine “eser” miktarlarda olduğu için olumsuz etkisi yoktur.
Sofra tuzu çoğunlukla iyot açısından zenginleştirilmiştir. Bundaki amaç, iyot eksikliğinin ve tiroit problemlerinin azaltılmasıdır. Bu yüzden pek çok ülkede yasal düzenlemeler yoluyla sofra tuzlarına iyot eklenmektedir.

Glüten tüketimi herkes için zararlı mı?
Nüfusun %1’inden azında görülen çölyak hastalarının glüteni beslenmelerinden çıkartmaları gerekir ve glüten intoleransı veya alerjisi bulunanların da hassasiyetlerine göre glütenden mümkün olduğunda uzak durmalarında fayda vardır. Ancak bu glüten hasta ettiği için değil, hastalığı veya alerjisi olan insanların vücudunun glütene tepki vermesi dolayısıyla ortaya çıkan bir gerekliliktir.

Glüten, düşman ilan edilmesi ise hatalı bir modadır. Glüten buğday, arpa, çavdar gibi tahıllarda bulunan bir proteindir. Bilim dünyası “tam buğday ürünlerine ilişkin olumsuz görüşleri destekleyen hiçbir veri olmadığı ve tüketiminin de şişmanlıkla ilişkilendirilemeyeceği” belirtmektedir.

Bunun ötesinde eğer glütenle ilgili bir sorununuz yoksa glütensiz beslenme sağlığı tehdit edici bile olabilir. Amerikan Kalp Birliği’nin 2017’deki toplantısının raporunda düşük glutenli beslenmenin tip 2 şeker hastalığı riskini artırabileceği bildirmiştir.

Glütensiz beslenmenin uzun sürede insan sağlığına etkilerini gösteren en büyük çalışma ise 2017’de British Medical Journal’da yayınlanmıştır. 110 binden fazla sağlık çalışanının, 25 yılı aşkın bir süre izlendiği bu çalışmada, glüten nedeniyle tam tahılları tüketmeyen bireylerin kalp hastalığı riskinin arttığı gösterilmiş ve sonucunda “Çölyak hastalığı olmayan kişiler glütensiz diyete teşvik edilmemelidir” notu düşülmüştür.

Zeytinyağıyla yemek pişirmek ya da kızartma yapmak sakıncalı mı?
Raflarda çeşitli zeytinyağları (natürel sızma, natürel birinci, riviera gibi) var ve bunların her biri pişirmeye de kızartmaya da uygundur. Önemli olan yağların defalarca kullanmamadır.

Öte yandan sızmaları sıcak yemeklerde kullanmak sakıncalı olmasa da biraz yazık olur. Çünkü ısıl işlem faydalı bazı fenolik bileşenleri kaybetmemize neden olmaktadır. Aslında pişirme kızartma gibi işlemleri rivieara zeytinyağı veya diğer bitkisel yağlarla yapılması daha hesaplı bir çözümdür.

Işınlanmış gıdaları tüketmek, vücutta radyasyon birikimine yol açar mı?
Gıda ışınlamanın amaçları; hasta edici mikroorganizmaları yok etmek ve gıdayı çürüten mikroorganizmaları azaltmak, parazitleri elimine etmek, küflenme, filizlenme, çimlenme ve tomurcuklanmayı önlemek, olgunlaşmayı geciktirmek ve gıdamızın daha uzun süre güvenle saklanabilmesini sağlamaktır.

Radyasyon kelimesi insanları korkutsa da gıda ışınlanmasında bu gereksiz bir korkudur. Bu uygulamanın etkileri 30 yılı aşkın süredir dünya çapında bilimsel kurumlar tarafından araştırılmış ve ışınlanan gıdaların hiçbir şekilde radyoaktif olmadığı, radyasyon yaymadığı ve kalıntı barındırmadığı ortaya konmuştur.

Dünya Sağlık Örgütü (WHO), ABD Tarım ve Gıda Örgütü (FDA), Uluslararası Atom Enerjisi Kurumu (IAEA), Hastalık Kontrol ve Önleme Merkezleri (CDC) ile ülkemizdeki kamusal ve bilimsel otoriteler uygun teknolojilerle ışınlanan gıdaların hem güvenli hem de beslenme açısından yeterli olduğu sonucuna varmıştır.
Hatta NASA astronotları uzay yolculukları sırasında herhangi bir gıda kaynaklı hastalığa yakalanmamak için ışınlanmayla sterilize edilmiş gıdaları tüketmektedirler.











